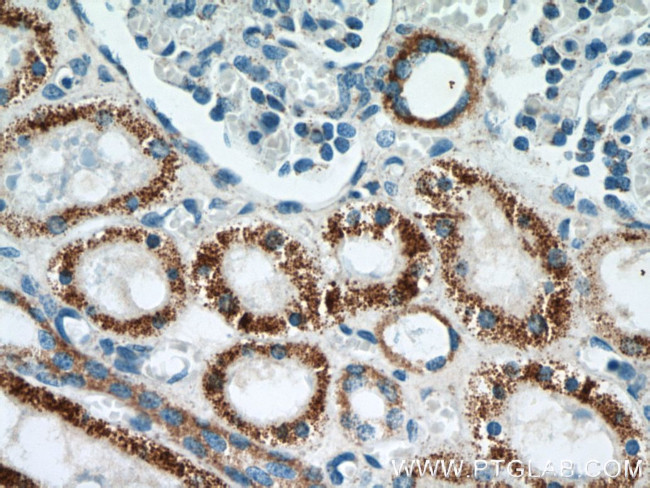
TST Antibody in Immunohistochemistry (Paraffin) (IHC (P))

Search
Proteintech
TST Monoclonal Antibody (2A6C5)
{{$productOrderCtrl.translations['antibody.pdp.commerceCard.promotion.promotions']}}
{{$productOrderCtrl.translations['antibody.pdp.commerceCard.promotion.viewpromo']}}
{{$productOrderCtrl.translations['antibody.pdp.commerceCard.promotion.promocode']}}: {{promo.promoCode}} {{promo.promoTitle}} {{promo.promoDescription}}. {{$productOrderCtrl.translations['antibody.pdp.commerceCard.promotion.learnmore']}}
产品信息
66018-1-IG
种属反应
已发表种属
宿主/亚型
分类
类型
克隆号
抗原
偶联物
形式
浓度
规格
纯化类型
保存液
内含物
保存条件
运输条件
产品详细信息
Immunogen sequence: MVHQVLYRA LVSTKWLAES IRTGKLGPGL RVLDASWYSP GTREARKEYL ERHVPGASFF DIEECRDTAS PYEMMLPSEA GFAEYVGRLG ISNHTHVVVY DGEHLGSFYA PRVWWMFRVF GHRTVSVLNG GFRNWLKEGH PVTSEPSRPE PAVFKATLDR SLLKTYEQVL ENLESKRFQL VDSRSQGRFL GTEPEPDAVG LDSGHIRGAV NMPFMDFLTE DGFEKGPEEL RALFQTKKVD LSQPLIATCR KGVTACHVAL AAYLCGKPDV AVYDGSWSEW FRRAPPESRV SQGKSEKA (1-297 aa encoded by BC010148)
靶标信息
The product of this gene is a mitochondrial matrix enzyme that is encoded by the nucleus. It may play roles in cyanide detoxification, the formation of iron-sulfur proteins, and the modification of sulfur-containing enzymes. The gene product contains two highly conservative domains (rhodanese homology domains), suggesting these domains have a common evolutionary origin.
仅用于科研。不用于诊断过程。未经明确授权不得转售。
生物信息学
蛋白别名: epididymis secretory sperm binding protein; LL22NC01-146D10.3; MGC19578; Rhodanese; Thiosulfate sulfurtransferase; thiosulfate sulfurtransferase (rhodanese); thiosulfate sulfurtransferase, mitochondrial; Thiosulfate sulphurtransferase (rhodanese); TST; unnamed protein product
基因别名: RDS; RHODAN; Rhodanese; TST
UniProt ID: (Human) Q16762, (Rat) P24329, (Mouse) P52196
Entrez Gene ID: (Human) 7263, (Rat) 25274, (Mouse) 22117